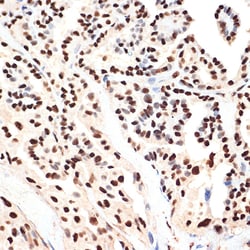
Invitrogen PHAPI2 Recombinant Rabbit Monoclonal Antibody (4A8E5) 100 &mu;L;
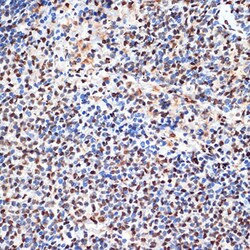
Invitrogen PHAPI2 Recombinant Rabbit Monoclonal Antibody (4A8E5) 100 &mu;L;

missing translation for 'onlineSavingsMsg'
Learn More
Learn More
Invitrogen™ PHAPI2 Recombinant Rabbit Monoclonal Antibody (4A8E5)


Rabbit Recombinant Monoclonal Antibody
Brand: Invitrogen™ MA538073
This item is not returnable.
View return policy
Description
Positive Samples: A-549, PC-3, RAW264.7, U-937, Mouse testis Immunogen sequence: MDMKRRIHLE LRNRTPAAVR ELVLDNCKSN DGKIEGLTAE FVNLEFLSLI NVGLISVSNL PKLPKLKKLE LSENRIFGGL DMLAEKLPNL THLNLSGNKL.
Multifunctional protein working as a cell cycle progression factor as well as a cell survival factor. Required for the progression from the G1 to the S phase. Anti-apoptotic protein which functions as a caspase-3 inhibitor. Has no phosphatase 2A (PP2A) inhibitor activity.
Specifications
| PHAPI2 | |
| Recombinant Monoclonal | |
| 1.22 mg/mL | |
| PBS with 0.05% BSA, 50% glycerol and 0.02% sodium azide; pH 7.3 | |
| Q92688, Q9EST5, Q9EST6 | |
| ANP32B | |
| A synthetic peptide corresponding to a sequence within amino acids 1-100 of human ANP32B (Q92688). | |
| 100 μL | |
| Primary | |
| Human, Mouse, Rat | |
| Antibody | |
| IgG |
| ELISA, Immunohistochemistry (Paraffin), Western Blot, Immunocytochemistry | |
| 4A8E5 | |
| Unconjugated | |
| ANP32B | |
| 2410015B15Rik; acidic (leucine-rich) nuclear phosphoprotein 32 family, member B; acidic leucine-rich nuclear phosphoprotein 32 family member B; acidic nuclear phosphoprotein 32 family member B; acidic nuclear phosphoprotein 32 family, member B; acidic protein rich in leucines; Anp32b; APRIL; OTTHUMP00000063770; Pal31; PHAPI2; PHAPI2a; proliferation related acidic leucine rich protein PAL31; proliferation-related acidic leucine-rich protein PAL31; Putative HLA-DR-associated protein I-2; silver-stainable protein SSP29; SSP29; TNF superfamily member 13 | |
| Rabbit | |
| Affinity Chromatography | |
| RUO | |
| 10541, 170724, 67628 | |
| -20°C, Avoid Freeze/Thaw Cycles | |
| Liquid |
Product Content Correction
Your input is important to us. Please complete this form to provide feedback related to the content on this product.
Product Title
Spot an opportunity for improvement?Share a Content Correction